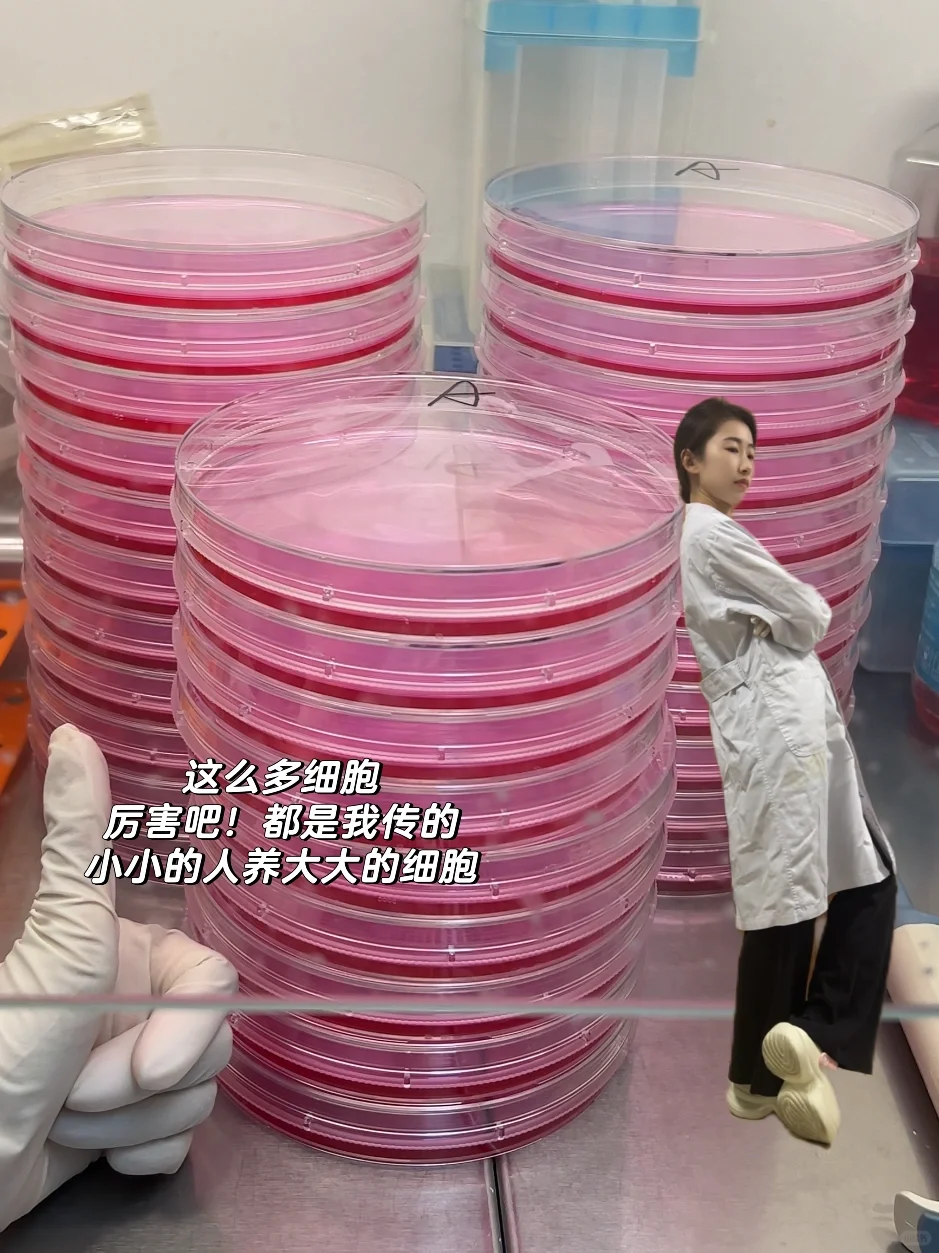
去实验室拍小人国写真！附实验仪器使用教程

在实验室的都去拍小人国写真!
也算是开学打卡的方式呢
博一老学姐整理了这些实验仪器使用教程
(师姐们刷到请转给研一师妹看)
边看小人国写真边学实验仪器的使用
知识以一种丝滑的方式进入脑子?
一、离心机
❗️贵,危险!
✔️头等大事是配平!不配平会损坏机器,甚至东西飞出来伤人,12000rpm东西飞出来人直接?了(夸张手法)
二、-80度冰箱
❗️贵!重要!里面冻的细胞是师兄师姐的毕业论文!
✔️初次使用带好棉手套,防止冻伤
使用后将门关紧,确保关好了再离开,一旦温度低于-80,细胞复苏率很低,甚至相当于不能用了
三、微波炉
❗️危险!容易爆?
✔️用来快速加热帮助溶解,比如凝胶的制备,使用时瓶盖不要拧紧,实验用的微波炉不能再用于热食物(实验室很多试剂都有du)
四、恒温摇床
❗️一般贵,不危险
✔️记得把门关紧,不要误关电源
五、金属浴
❗️不贵,危险
✔️温度可高达100度,使用后及时关闭,自己打开的自己关闭
六、分析天平
❗️不贵,不危险,相当于一个秤
✔️称量时要关闭左右玻璃门,在封闭的环境中更准确,称量完撒在桌子和仪器上的试剂及时擦干净
七、移液器
❗️贵,易损坏
✔️移液器就是实验人的武器,一定要正确使用,好好爱护,使用精准的移液器,实验就成功一半啦,我用Gilson移液枪还是很准的,注意使用后调至zui大量程,能大大延长移液器使用寿命,定期(半年或一年)校准一次即可
#研究生 #科研小白 #生物实验 #实验室仪器 #实验室日常 #医学研究生 #细胞实验 #移液器 #Gilson移液器 #PipetmanL #你觉得实验室有趣吗![PK]#
也算是开学打卡的方式呢
博一老学姐整理了这些实验仪器使用教程
(师姐们刷到请转给研一师妹看)
边看小人国写真边学实验仪器的使用
知识以一种丝滑的方式进入脑子?
一、离心机
❗️贵,危险!
✔️头等大事是配平!不配平会损坏机器,甚至东西飞出来伤人,12000rpm东西飞出来人直接?了(夸张手法)
二、-80度冰箱
❗️贵!重要!里面冻的细胞是师兄师姐的毕业论文!
✔️初次使用带好棉手套,防止冻伤
使用后将门关紧,确保关好了再离开,一旦温度低于-80,细胞复苏率很低,甚至相当于不能用了
三、微波炉
❗️危险!容易爆?
✔️用来快速加热帮助溶解,比如凝胶的制备,使用时瓶盖不要拧紧,实验用的微波炉不能再用于热食物(实验室很多试剂都有du)
四、恒温摇床
❗️一般贵,不危险
✔️记得把门关紧,不要误关电源
五、金属浴
❗️不贵,危险
✔️温度可高达100度,使用后及时关闭,自己打开的自己关闭
六、分析天平
❗️不贵,不危险,相当于一个秤
✔️称量时要关闭左右玻璃门,在封闭的环境中更准确,称量完撒在桌子和仪器上的试剂及时擦干净
七、移液器
❗️贵,易损坏
✔️移液器就是实验人的武器,一定要正确使用,好好爱护,使用精准的移液器,实验就成功一半啦,我用Gilson移液枪还是很准的,注意使用后调至zui大量程,能大大延长移液器使用寿命,定期(半年或一年)校准一次即可
#研究生 #科研小白 #生物实验 #实验室仪器 #实验室日常 #医学研究生 #细胞实验 #移液器 #Gilson移液器 #PipetmanL #你觉得实验室有趣吗![PK]#


